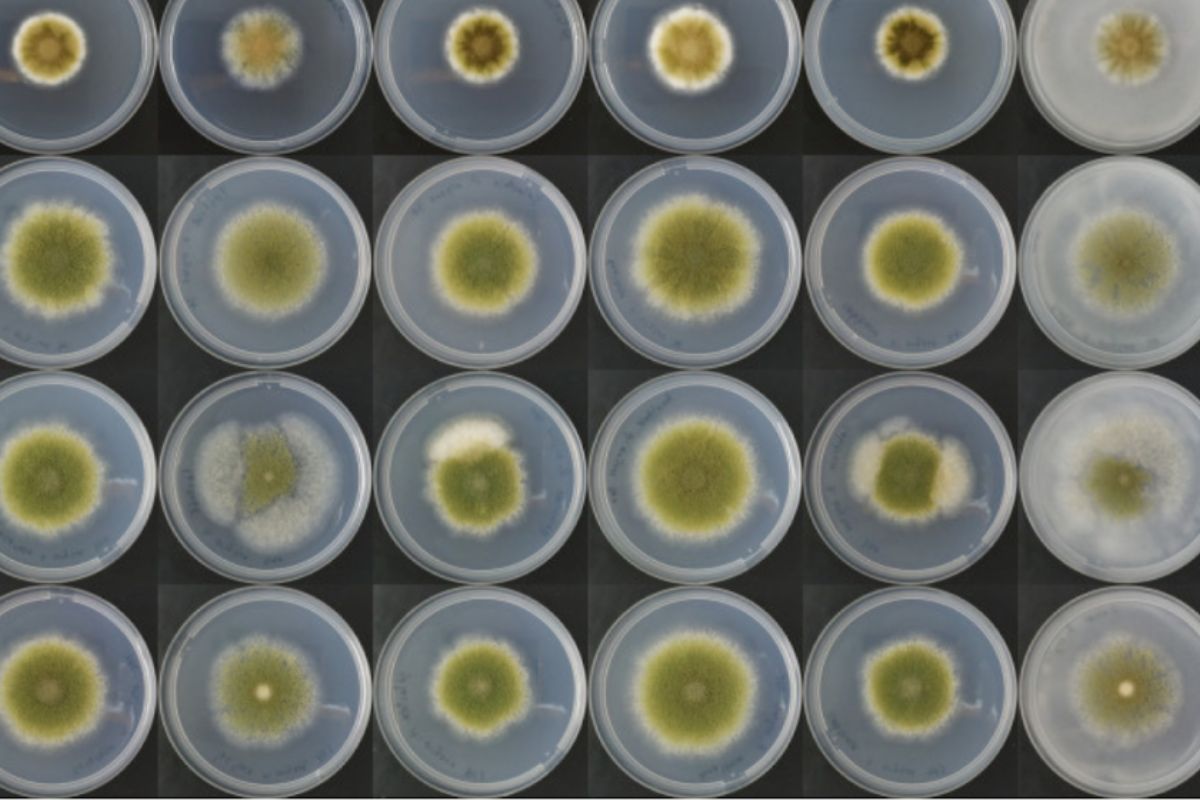
Pesquisas mostram que a proteína do fungo pode transformar a alimentação global com micoproteínas de alta qualidade e baixo impacto ambiental, impulsionando a biotecnologia alimentar e a carne alternativa

Research Shows That Fungal Protein Can Transform Global Diet with High-Quality and Low-Environmental-Impact Microproteins, Boosting Food Biotechnology and Alternative Meat
Fungal protein has gained ground in discussions about the future of food, according to an article published.
In a scenario of climate change and increasing demand for sustainable food, fungi emerge as protagonists of a silent food revolution.
Microproteins, produced from the mycelium, the structure that supports the fungus, combine high nutritional value, meat-like texture, and a production process with low environmental impact.
-
While Russia dominates the global wheat market, Brazil emerges as an unexpected competitor in the Cerrado, offering grain available in July and August when stocks in the Northern Hemisphere are at their lowest point of the year.

-
China returned almost 20 Brazilian ships with soybeans, but now everything could change: the country that buys 80% of the grain is considering relaxing regulations after impurities held up shipments of thousands of tons and caused million-dollar losses.

-
The drought of the cerrado was considered an enemy of wheat, but Brazilian scientists turned the lack of rain into a competitive advantage by creating a grain with quality that is already attracting the attention of international mills around the world.

-
THE OWNER of Brazil: a farmer who came from laundries, created an ’empire’ and today runs a company valued at R$ 42 billion after tripling its value in less than a year and receiving a billion-dollar investment from the USA.

This innovation has captured the interest of researchers, companies, and investors who see this resource as a promising solution to the challenges of food security and global sustainability.
The market, currently estimated at US$ 7.2 billion, is expected to exceed US$ 32 billion by 2032, driven by advances in precision fermentation and food biotechnology.
Microproteins and Precision Fermentation: How Fungi Are Transforming Food Production
The combination of microproteins and precision fermentation has redefined the concept of alternative meat.
Researcher André Damasio from Unicamp explains that filamentous fungi and yeasts are being converted into “cell factories” capable of generating recombinant proteins with low environmental impact.
Companies like Quorn, Meati, and Enough are already producing at an industrial scale, catering to both the B2B market and end consumers.
These proteins present 45% to 48% protein content and 22% to 35% fiber, ensuring nutritional value and texture comparable to animal meat.
Moreover, growing fungi requires less land and water, emitting significantly fewer greenhouse gases than conventional livestock.
This efficiency is transforming fungal protein into one of the most sustainable sources of protein on the planet.
In the last five years, investments in biomass fermentation, the foundational technology for producing mycelium, have outpaced those in cultivated meat.
€ 628 million have been invested in fungi, compared to € 459 million allocated to lab-produced meat.
This trend reflects growing investor confidence in food biotechnology, which combines scalability, sustainability, and consumer acceptance.
Food Biotechnology and Genetic Engineering: The Role of New Technologies in Fungal Protein
Food biotechnology has enabled remarkable advances in the production of fungal protein.
Techniques such as CRISPR-Cas9 genetic editing and so-called omics technologies, which include transcriptomic and proteomic analyses, are optimizing fungal strains to improve productivity, flavor, and texture.
Agricultural engineer Gabriel Mascarin from Embrapa Meio Ambiente (SP) emphasizes that these advances range from strain engineering to downstream processing, which is responsible for protein purification.
These innovations also enhance food safety by allowing traceability and contaminant control.
Still, the expert warns that clinical studies are lacking to evaluate the bioavailability of amino acids and the impact of fungal protein on satiety and long-term health.
Standardizing nutritional values and monitoring toxins and heavy metals are crucial before these products are widely popularized.
With this technological advancement, the fungi Fusarium venenatum and Aspergillus oryzae stand out for their high efficiency in producing microproteins.
Although they grow more slowly than yeasts, they yield high returns and have sensory characteristics desired by the food industry.
This combination of biotechnology and precision fermentation positions fungal protein as a pillar of a new era of food production.
Alternative Meat and Consumer Acceptance: The Challenges and Opportunities of Fungal Protein
The microprotein-based alternative meat market is growing at annual rates close to 10.78%, reflecting the increasing interest in sustainable diets.
However, consumer acceptance is still a sensitive point. Factors such as taste, preparation, and health perception determine the willingness to include fungal protein in dietary routines.
Companies like Quorn and Meati invest in sensory research and hybrid products that combine plant proteins and mycelium, seeking to broaden the target audience beyond vegans.
These products offer advantages such as neutral flavor, fibrous texture, and low fat content, characteristics that bring the consumption experience closer to traditional meat.
Despite this, there are technical limitations, such as the low solubility of mycelium, which restricts its use in liquid foods.
Startups like Nature’s Fynd have been exploring solutions to create mycelium-based yogurts, demonstrating the versatility of this raw material.
The expansion of these applications depends on regulatory adjustments and increased public trust, which still associates “fungus” with something exotic or unconventional.
In addition to acceptance, international regulation influences the growth rate of the sector. In the United States, the FDA approved the consumption of microproteins in 2001, but has yet to establish specific intake guidelines.
These foods are not recommended for children under three years old, due to their high fiber content and lower energy density.
However, studies indicate benefits such as cholesterol reduction, improved satiety, and glycemic control, reinforcing their potential as components of a balanced diet.
Reduced Environmental Impact and the Role of Fungal Protein in Global Food Security
Fungal protein is not just a food innovation; it is an environmental mitigation strategy. Mycelium cultivation has low CO₂ emissions, reduced water footprint, and high productive circularity, as it uses agricultural byproducts as substrates.
Even with the energy consumption of submerged fermentation, the total impact is lower than that of traditional livestock.
Researcher Paula Cunha from Unicamp states that fungal biotechnology should be viewed as a protein complement, not a complete substitute for meat.
By integrating microproteins into existing food chains, it is possible to diversify nutritional sources, reduce pressure on natural resources, and strengthen the resilience of agro-industrial systems in the face of climate change.
This approach directly addresses global sustainability and food security goals, supported by institutions such as the FAO.
Fungal protein, due to its requirement for less land and water and lower greenhouse gas emissions, aligns with the Sustainable Development Goals (SDGs), especially SDG 2 (zero hunger) and SDG 13 (climate action).
In the economic context, food biotechnology with fungi stands out for attracting significant investments from funds and corporations in the food and energy sectors.
The technological advancement and scalability potential make this alternative not only environmentally advantageous but also financially attractive, consolidating fungal protein as one of the pillars of future food.

 Portuguese
Portuguese  English
English  Spanish
Spanish

I must say this article is extremely well written, insightful, and packed with valuable knowledge that shows the author’s deep expertise on the subject, and I truly appreciate the time and effort that has gone into creating such high-quality content because it is not only helpful but also inspiring for readers like me who are always looking for trustworthy resources online. Keep up the good work and write more. i am a follower.
I must say this article is extremely well written, insightful, and packed with valuable knowledge that shows the author’s deep expertise on the subject, and I truly appreciate the time and effort that has gone into creating such high-quality content because it is not only helpful but also inspiring for readers like me who are always looking for trustworthy resources online. Keep up the good work and write more. i am a follower.
thanks my friend